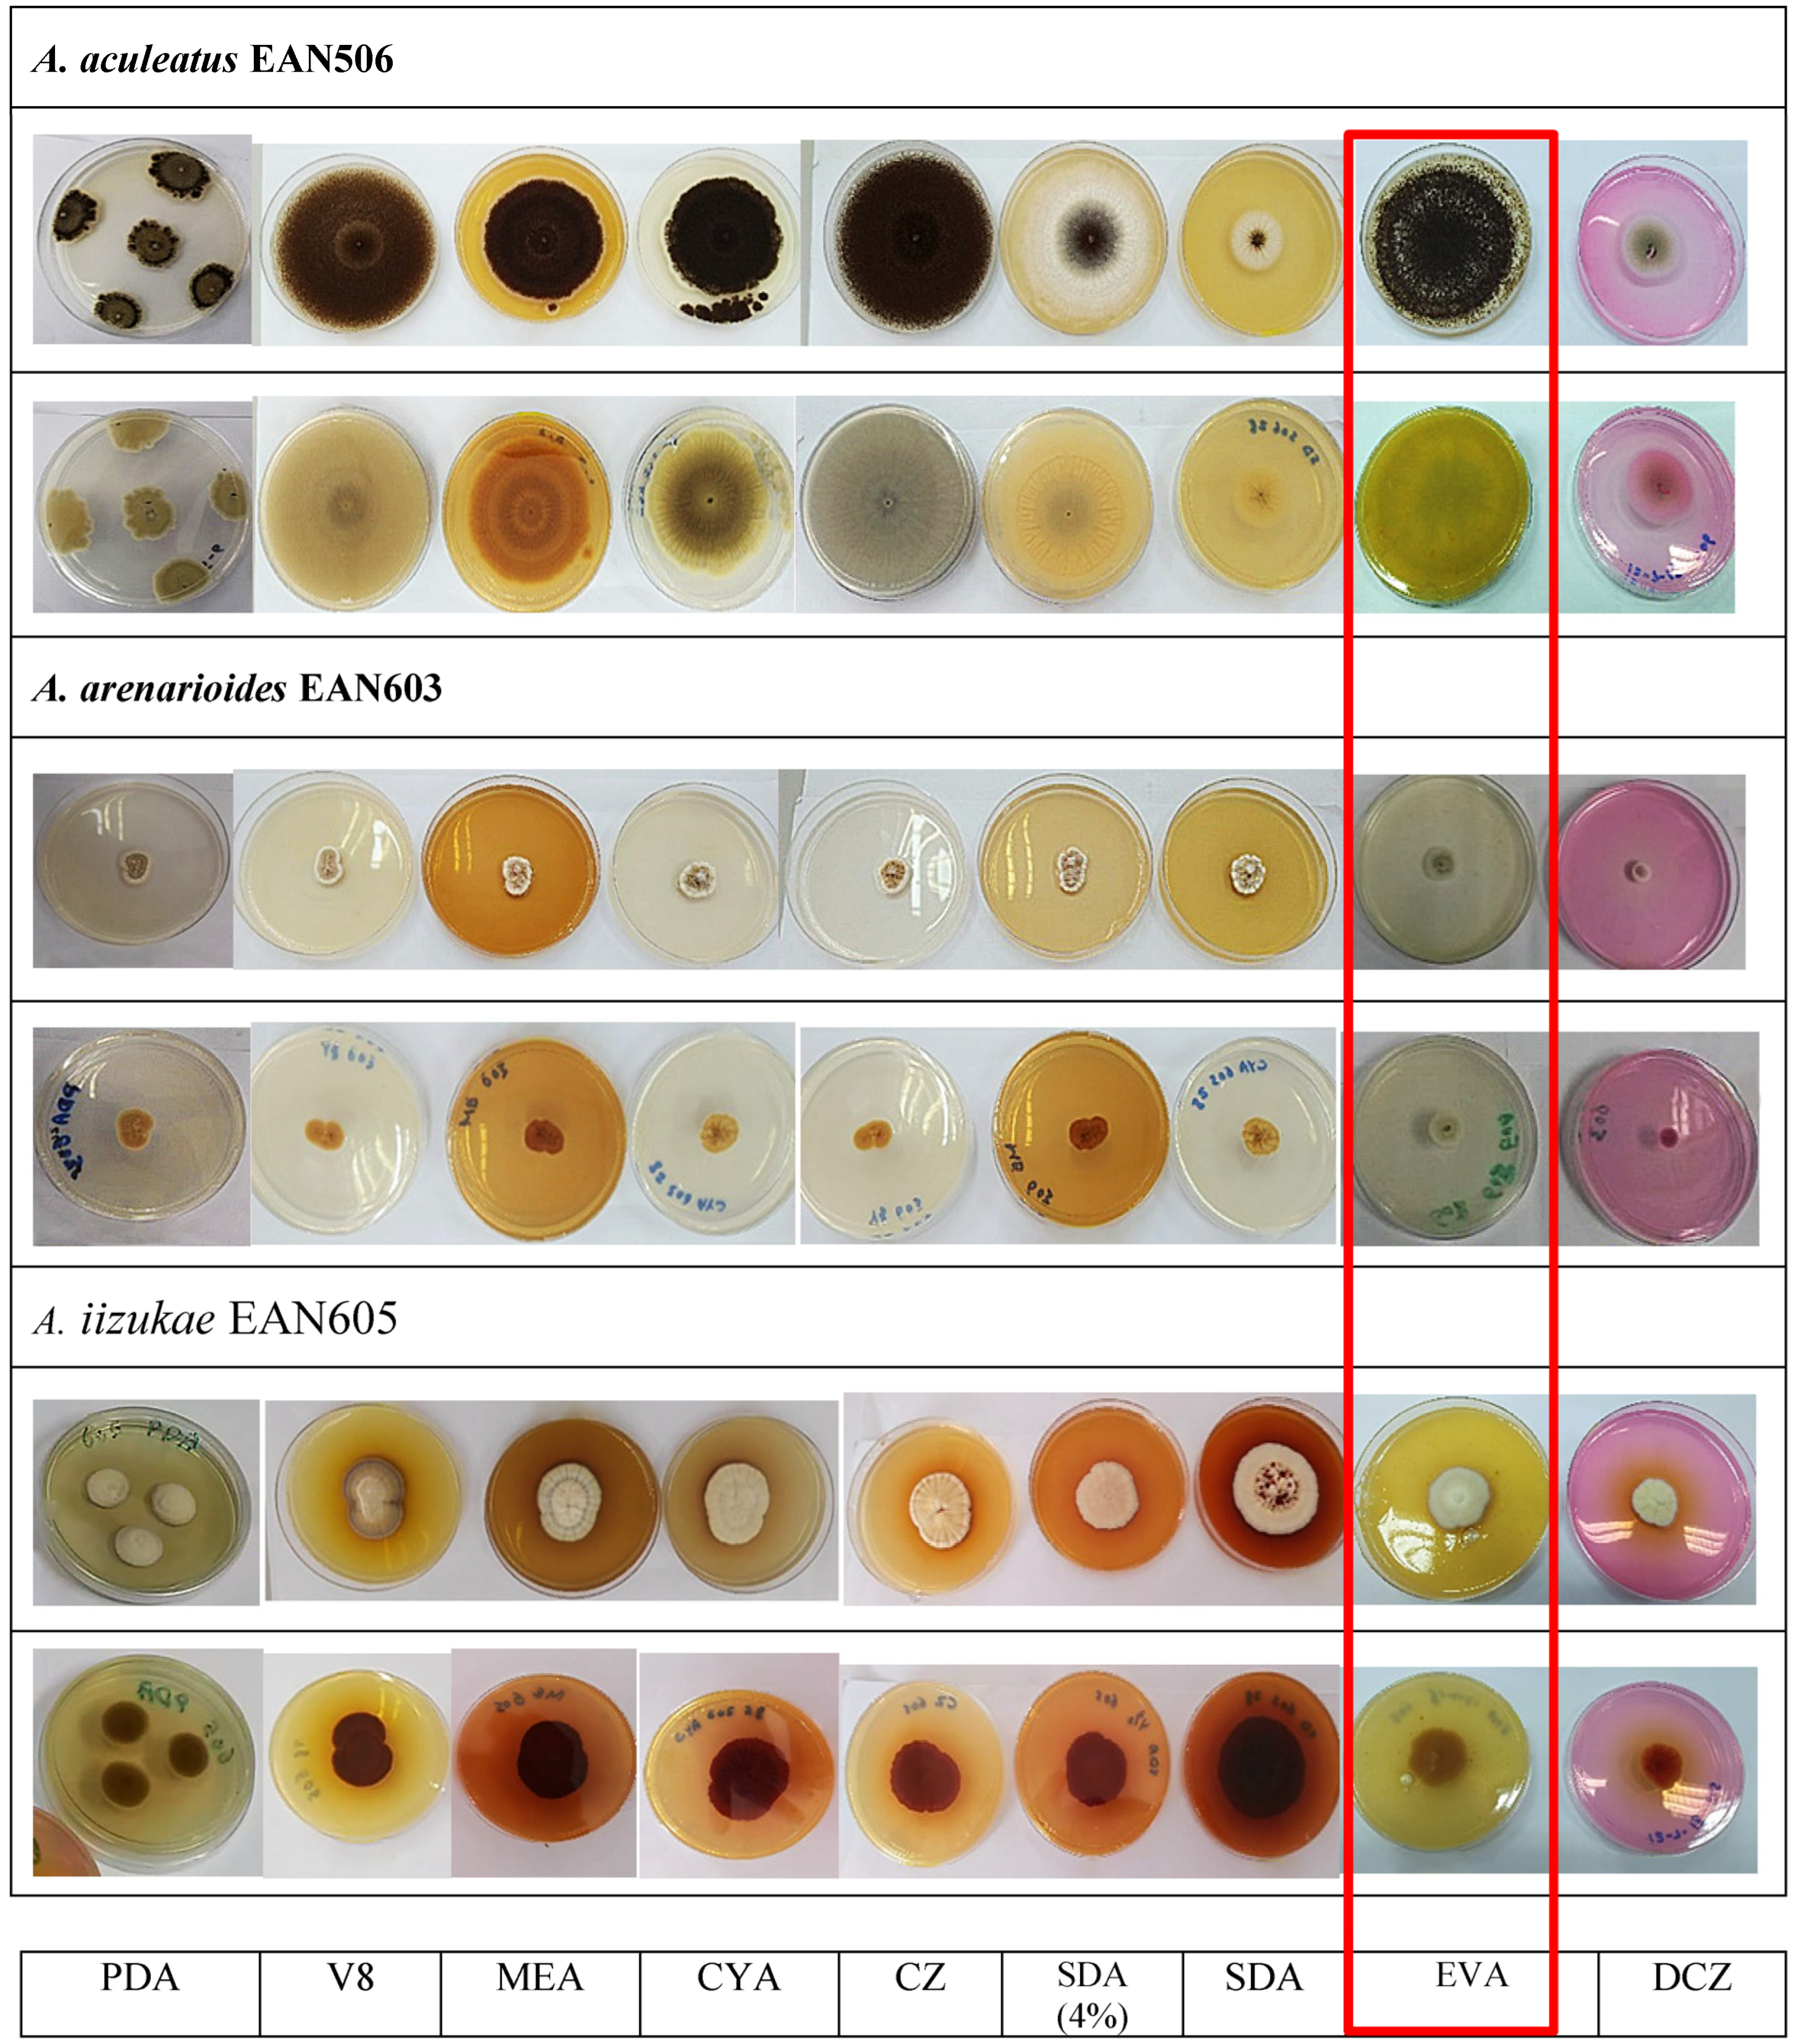
Sustainability 15 05902 g003

New Fungal Strains from Peat Soil in Malaysia: Morphological and Molecular Characteristics
Abstract
1. Introduction
2. Materials and Methods
2.1. Peat Soil Sample
2.2. Media Preparation
2.3. Fungal Strains Isolation and Purification from Soil Samples
2.4. Phenotypic and Molecular Analysis of Fungi Isolated from Peatland Samples
2.5. Raman Spectroscopy
3. Results and Discussion
3.1. Fungal Isolates from Peat Soil
3.2. Culture Morphology of the Fungal Isolates from Peat Soil
3.2.1. Aspergillus spp.
3.2.2. Penicillium spp.
3.2.3. Other Fungal Isolates
3.3. Microscopic Morphology of the Fungal Isolates from Peat Soil
3.4. Molecular Characteristics of Fungal Isolates from Peat Soil
3.5. Chemical Structure of the Fungal Mycelium
4. Conclusions
Supplementary Materials
Author Contributions
Funding
Institutional Review Board Statement
Informed Consent Statement
Data Availability Statement
Acknowledgments
Conflicts of Interest
References
- Gaitnieks, T.; Silbauma, L.; Muižnieks, I.; Zaļuma, A.; Kļaviņa, D.; Burņeviča, N.; Grosberga, M.; Lazdiņš, A.; Piri, T. Spread of Heterobasidion genotypes in Norway spruce stands on drained peat soil in Latvia. Can. J. For. Res. 2022, 52, 499–510. [Google Scholar] [CrossRef]
- Hawksworth, D.L.; Lücking, R. Fungal diversity revisited: 2.2 to 3.8 million species. Microbiol. Spectr. 2017, 5. [Google Scholar] [CrossRef] [PubMed]
- Blackwell, M. The Fungi: 1, 2, 3… 5.1 million species? Am. J. Bot. 2011, 98, 426–438. [Google Scholar] [CrossRef] [PubMed]
- Gams, W. Biodiversity of soil-inhabiting fungi. Biodivers. Conserv. 2007, 16, 69–72. [Google Scholar] [CrossRef]
- Latiffah, Z.; Nurul Izzati, H.; Baharuddin, S. Fusarium species isolated from peat soil of Pondok Tanjung and Sungai Beriah, Perak. Malays. J. Microbiol. 2010, 6, 102–105. [Google Scholar] [CrossRef]
- Karim, N.F.A.; Mohd, M.; Nor, N.M.I.M.; Zakaria, L. Saprophytic and potentially pathogenic Fusarium species from peat soil in Perak and Pahang. Trop. Life Sci. Res. 2016, 27, 1–20. [Google Scholar]
- Kin, P.K.; Azmi, W.A.; Kamarudin, N.; Ali, S.; Moslim, R. The occurrence of entomopathogenic fungi on mineral and peat soils in Peninsular Malaysia, American. J. Agric. Biol. Sci. 2017, 12, 1–12. [Google Scholar] [CrossRef]
- Omar, F.N.; Ismael, N.H.; Ali, S.R.A. Fungi associated with deep peat soil Sarawak. In Proceedings of the UMT 11th International Annual Symposium on Sustainability Science and Management, Kuala Terengganu, Malaysia, 9–11 July 2012; pp. 239–245. [Google Scholar]
- Allen, L.V., Jr. Quality Control: Water Activity Considerations for Beyond-use Dates. Int. J. Pharm. Compd. 2018, 22, 288–293. [Google Scholar]
- Khan, S.; Ali, S.A.; Ali, A.S. Biodegradation of low-density polyethylene (LDPE) by mesophilic fungus ‘Penicillium citrinum’ isolated from soils of plastic waste dump yard, Bhopal, India. Environ. Technol. 2022, 1–15. [Google Scholar] [CrossRef]
- Ruiz-Dueñas, F.J.; Morales, M.; García, E.; Miki, Y.; Martínez, M.J.; Martínez, A.T. Substrate oxidation sites in versatile peroxidase and other basidiomycete peroxidases. J. Exp. Bot. 2008, 60, 441–452. [Google Scholar] [CrossRef]
- Cañas, A.I.; Camarero, S. Laccases and their natural mediators: Biotechnological tools for sustainable eco-friendly processes. Biotechnol. Adv. 2010, 28, 694–705. [Google Scholar] [CrossRef] [PubMed]
- Lee, H.; Jang, Y.; Choi, Y.S.; Kim, M.J.; Lee, J.; Lee, H.; Hong, J.H.; Lee, Y.M.; Kim, G.H.; Kim, J.J. Biotechnological procedures to select white rot fungi for the degradation of PAHs. J. Microbiol. Methods 2014, 97, 56–62. [Google Scholar] [CrossRef] [PubMed]
- Talaat, W.I.A.W.; Tahir, N.M.; Husain, M.L. Sustainable management of forest biodiversity and the present Malaysian policy and legal framework. J. Sustain. Dev. 2012, 5, 76. [Google Scholar] [CrossRef]
- Paterson, R.R.M.; Lima, N. Climate change affecting oil palm agronomy, and oil palm cultivation increasing climate change, require amelioration. Ecol. Evol. 2018, 8, 452–461. [Google Scholar] [CrossRef]
- Evans, C.S.; Hedger, J.N. November. Degradation of plant cell wall polymers. In British Mycological Society Symposium Series; Elsevier: Amsterdam, The Netherlands, 2001; Volume 23, pp. 1–26. [Google Scholar]
- Lodge, D.J.; Cantrell, S. Fungal communities in wet tropical forests: Variation in time and space. Can. J. Bot. 1995, 73, 1391–1398. [Google Scholar] [CrossRef]
- Al-Enazi, N.M.; Awaad, A.S.; Al-Othman, M.R.; Al-Anazi, N.K.; Alqasoumi, S.I. Isolation, identification and anti-candidal activity of filamentous fungi from Saudi Arabia soil. Saudi Pharm. J. 2018, 26, 253–257. [Google Scholar] [CrossRef] [PubMed]
- APHA. Standard Methods for the Examination of Water and Waste Water, 22nd ed.; American Public Health Association, American Water Works Association, Water Environment Federation: Washington, DC, USA, 2012. [Google Scholar]
- Collee, J.G.; Miles, R.S.; Watt, B. Tests for the Identification of Bacteria. In Mackie & McCartney Practical Medical Microbiology, 14th ed.; Collee, J.G., Marmion, B.P., Fraser, A.G., Simmons, A., Eds.; Churchill Livingstone: New York, NY, USA, 1996; pp. 131–151. [Google Scholar]
- Noman, E.; Talip, B.A.; Al-Gheethi, A.; Mohamed, R.; Nagao, H. Decolourisation of dyes in greywater by mycoremediation and mycosorption process of fungi from peatland; primary study. Mater. Today Proc. 2020, 31, 23–30. [Google Scholar] [CrossRef]
- Noman, E.; Al-Gheethi, A.A.; Rahman, N.K.; Talip, B.; Mohamed, R.; Kadir, O.A. Single spore isolation as a simple and efficient technique to obtain fungal pure culture. In IOP Conference Series: Earth & Environmental Science; IOP Publishing: Bristol, UK, 2018; Volume 140, p. 012055. [Google Scholar]
- Rifal, M.A. A revision of the genus Trichoderma. Mycol. Pap. 1969, 116, 1–55. [Google Scholar]
- Watanabe, T. Pictorial Atlas of Soil and Seed Fungi: Morphologies of Cultured Fungi and Key to Species, 2nd ed.; CRC: Boca Raton, FL, USA, 2002. [Google Scholar]
- Samson, R.A.; Houbraken, J.; Thrane, U.; Frisvad, J.C.; Andersen, B. Food and indoor fungi. In CBS Laboratory Manual Series 2; CBS-Fungal Biodiversity Centre: Utrecht, The Netherlands, 2010. [Google Scholar]
- Robert, A.S.; János, V.; Christian, F.J. Taxonomic Studies on the Genus Aspergillus–DTU Orbit; CBS-KNAW Fungal Biodiversity Centre (Studies in Mycology): Utrecht, The Netherlands, 2011. [Google Scholar]
- Silva, D.M.; Batista, L.R.; Rezende, E.F.; Fungaro, M.H.P.; Sartori, D.; Alves, E. Identification of fungi of the genus Aspergillus section nigri using polyphasic taxonomy. Braz. J. Microbiol. 2011, 42, 761–773. [Google Scholar] [CrossRef]
- Campbell, C.K.; Johnson, E.M.; Warnock, D.W. Identification of Pathogenic Fungi, 2nd ed.; John Wiley and Sons: Hoboken, NJ, USA, 2013. [Google Scholar]
- NMRC; Mycology Online. National Mycology Reference Centre; the University of Adelaide: Adelaide, South Australia, 2019. [Google Scholar]
- Fell, J.W.; Boekhout, T.; Fonseca, A.; Scorzetti, G.; Statzell-Tallman, A. Biodiversity and systematics of basidiomycetous yeasts as determined by large-subunit rDNA D1/D2 domain sequence analysis. Int. J. Syst. Evol. Microbiol. 2000, 50, 1351–1371. [Google Scholar] [CrossRef]
- White, T.J.; Bruns, T.D.; Lee, S.; Taylor, J. Amplification and direct sequencing of fungal ribosomal RNA genes for phylogenetics. In PCR Protocols, a Guide to Methods and Applications; Innis, M.A., Gelfand, D.H., Sninsky, J.J., White, T.J., Eds.; Academic Press: San Diego, CA, USA, 1990; pp. 315–322. [Google Scholar]
- Samson, R.A.; Seifert, K.A.; Kuijpers, A.F.; Houbraken, J.A.M.P.; Frisvad, J.C. Phylogenetic analysis of Penicillium subgenus Penicillium using partial β-tubulin sequences. Stud. Mycol. 2004, 49, pp. 175–200. [Google Scholar]
- Lee, S.S.; Horak, E.; Alias, S.A.; Thi, B.K.; Nazura, Z.; Jones, E.B.G.; Nawawi, A. Checklist of Literature on Malaysian Macrofungi; Forest Research Institute Malaysia: Kuala Lumpur, Malaysia, 2008.
- Jurjević, Ž.; Kubátová, A.; Kolařík, M.; Hubka, V. Taxonomy of Aspergillus section Petersonii sect. nov. encompassing indoor and soil-borne species with predominant tropical distribution. Plant Syst. Evol. 2015, 301, 2441–2462. [Google Scholar] [CrossRef]
- Pinto, A.C.; Palomar, T.; Alves, L.C.; da Silva, S.H.M.; Monteiro, R.C.; Macedo, M.F.; Vilarigues, M.G. Fungal biodeterioration of stained-glass windows in monuments from Belém do Pará (Brazil). Int. Biodeterior. Biodegrad. 2019, 138, 106–113. [Google Scholar] [CrossRef]
- Laich, F.; Andrade, J. Penicillium pedernalense sp. nov., isolated from whiteleg shrimp heads waste compost. Int. J. Syst. Evol. Microbiol. 2016, 66, 4382–4388. [Google Scholar] [CrossRef] [PubMed]
- Hubka, V.; Nováková, A.; Kolařík, M.; Jurjević, Ž; Peterson, S.W. Revision of Aspergillus section Flavipedes: Seven new species and proposal of section Jani sect. nov. Mycologia 2015, 107, 169–208. [Google Scholar] [CrossRef]
- Saha, A.; Mandal, P.; Dasgupta, S.; Saha, D. Influence of culture media and environmental factors on mycelial growth and sporulation of Lasiodiplodia theobromae (Pat.) Griffon and Maubl. J. Environ. Biol. 2008, 29, 407. [Google Scholar] [PubMed]
- Choi, Y.W.; Hyde, K.D.; Ho, W.H. Single spore isolation of fungi. Fungal Divers. 1999, 3, 29–38. [Google Scholar]
- Peterson, S.W. Phylogenetic analysis of Aspergillus species using DNA sequences from four loci. Mycologia 2008, 100, 205–226. [Google Scholar] [CrossRef] [PubMed]
- Klich, M.A. Biogeography of Aspergillus species in soil and litter. Mycologia 2002, 94, 21–27. [Google Scholar] [CrossRef] [PubMed]
- Varga, J.; To’th, B.; Kocsube’, S.; Farkas, B.; Szaka’cs, G.; Te’ren, J.; Kozakiewicz, Z. Evolutionary relationships among Aspergillus terreus isolates and their relatives. Antonie Leeuwenhoek 2005, 88, 141–150. [Google Scholar] [CrossRef]
- El-Elimat, T.; Raja, H.A.; Graf, T.N.; Faeth, S.H.; Cech, N.B.; Oberlies, N.H. Flavonolignans from Aspergillus iizukae, a fungal endophyte of milk thistle (Silybum marianum). J. Nat. Prod. 2014, 77, 193–199. [Google Scholar] [CrossRef] [PubMed]
- Yuan, Z.L.; Rao, L.B.; Chen, Y.C.; Zhang, C.L.; Wu, Y.G. From pattern to process: Species and functional diversity in fungal endophytes of Abies beshanzuensis. Fungal Biol. 2011, 115, 197–213. [Google Scholar] [CrossRef]
- Shan, T.; Sun, W.; Lou, J.; Gao, S.; Mou, Y.; Zhou, L. Antibacterial activity of the endophytic fungi from medicinal herb, Macleaya cordata. Afr. J. Biotechnol. 2012, 11, 4354–4359. [Google Scholar]
- Macia’-Vicente, J.G.; Ferraro, V.; Burruano, S.; Lopez-Llorca, L.V. Fungal assemblages associated with roots of halophytic and non-halophytic plant species vary differentially along a salinity gradient. Microbiol. Ecol. 2012, 64, 668–679. [Google Scholar] [CrossRef] [PubMed]
- Kang, H.H.; Zhang, H.B.; Zhong, M.J.; Ma, L.Y.; Liu, D.S.; Liu, W.Z.; Ren, H. Potential antiviral xanthones from a Coastal Saline Soil Fungus Aspergillus iizukae. Mar. Drugs 2018, 16, 449. [Google Scholar] [CrossRef]
- Poitevin, C.G.; Porsani, M.V.; Poltronieri, A.S.; Zawadneak, M.A.C.; Pimentel, I.C. Fungi isolated from insects in strawberry crops act as potential biological control agents of Duponchelia fovealis (Lepidoptera: Crambidae). Appl. Entomol. Zool. 2018, 53, 323–331. [Google Scholar] [CrossRef]
- Li, L.J.; Li, T.X.; Kong, L.Y.; Yang, M.H. Antioxidant aromatic butenolides from an insect-associated Aspergillus iizukae. Phytochem. Lett. 2016, 16, 134–140. [Google Scholar] [CrossRef]
- Liu, D.; Yan, L.; Ma, L.; Huang, Y.; Pan, X.; Liu, W.; Lv, Z. Diphenyl derivatives from coastal saline soil fungus Aspergillus iizukae. Arch. Pharmacal Res. 2015, 38, 1038–1043. [Google Scholar] [CrossRef]
- Zhang, H.; Zhang, S.; He, F.; Qin, X.; Zhang, X.; Yang, Y. Characterisation of a manganese peroxidase from white-rot fungus Trametes sp. 48424 with strong ability of degrading different types of dyes & polycyclic aromatic hydrocarbons. J. Hazard. Mater. 2016, 320, 265–277. [Google Scholar]
- Won, E.J.; Shin, J.H.; Lim, S.C.; Shin, M.G.; Suh, S.P.; Ryang, D.W. Molecular identification of Schizophyllum commune as a cause of allergic fungal sinusitis. Ann. Lab. Med. 2012, 32, 375–379. [Google Scholar] [CrossRef]
- Chowdhary, A.; Randhawa, H.S.; Gaur, S.N.; Agarwal, K.; Kathuria, S.; Roy, P.; Klaassen, C.H.; Meis, J.F. Schizophyllum commune as an emerging fungal pathogen: A review and report of two cases. Mycoses 2013, 56, 1–10. [Google Scholar] [CrossRef]
- Kang, M.J.; Choi, Y.S.; Kim, S. A Comparison of the Ability of Fungal Internal Transcribed Spacers and D1/D2 Domain Regions to Accurately Identify Candida glabrata Clinical Isolates Using Sequence Analysis. Biomed. Sci. Lett. 2018, 24, 430–434. [Google Scholar] [CrossRef]
- Sang, H.K.; Choi, Y.P.; Yu, S.H. Phylogenetic analysis, morphology and pathogenicity of Penicillium spp. associated with blue mold of apple in Korea. Korean J. Agric. Sci. 2010, 37, 341–350. [Google Scholar]
- Visagie, C.M.; Hirooka, Y.; Tanney, J.B.; Whitfield, E.; Mwange, K.; Meijer, M.; Amend, A.S.; Seifert, K.A.; Samson, R.A. Aspergillus, Penicillium and Talaromyces isolated from house dust samples collected around the world. Stud. Mycol. 2014, 78, 63–139. [Google Scholar] [CrossRef] [PubMed]
- Bedi, A.; Singh, B.R.; Deshmukh, S.K.; Adholeya, A.; Barrow, C.J. An Aspergillus aculateus strain was capable of producing agriculturally useful nanoparticles via bioremediation of iron ore tailings. J. Environ. Manag. 2018, 215, 100–107. [Google Scholar] [CrossRef] [PubMed]
- Nyongesa, B.W.; Okoth, S.; Ayugi, V. Identification key for Aspergillus species isolated from maize and soil of Nandi County, Kenya. Adv. Microbiol. 2015, 5, 205. [Google Scholar] [CrossRef]
- Tanaka, K.; Harada, Y.; Barr, M.E. Trematosphaeria: Taxonomic concepts, new species from Japan and key to species. Fungal Divers. 2005, 19, 145–156. [Google Scholar]
- Freire, K.T.; Araújo-Magalhães, G.R.; Nascimento, S.S.; Paiva, L.M.; Barbosa, R.N.; Bezerra, J.D.; Souza-Motta, C.M. First report of Penicillium brasilianum Bat., P. cluniae Quintan., and P. echinulonalgiovense S. Abe ex Houbraken & RN Barbosa (Eurotiales, Aspergillaceae) as endophytes from a bromeliad in the Caatinga dry forest in Brazil. Check List 2020, 16, 1055. [Google Scholar]
- Mansouri, S.; Houbraken, J.; Samson, R.A.; Frisvad, J.C.; Christensen, M.; Tuthill, D.E.; Koutaniemi, S.; Hatakka, A.; Lankinen, P. Penicillium subrubescens, a new species efficiently producing inulinase. Antonie Van Leeuwenhoek 2013, 103, 1343–1357. [Google Scholar] [CrossRef]
- Dethoup, T.; Manoch, L.; Visarathanonth, N.; Chamswarng, C.; Kijjoa, A. Morphology and distribution of Talaromyces flavus from soil and potential use as a biological control agent against plant pathogenic fungi. Thai. J. Agric. Sci. 2007, 40, 37–50. [Google Scholar]
- Yilmaz, N.; Visagie, C.M.; Houbraken, J.; Frisvad, J.C.; Samson, R.A. Polyphasic taxonomy of the genus Talaromyces. Stud. Mycol. 2014, 78, 175–341. [Google Scholar] [CrossRef]
- Wong, S.Y.; Wong, K. Penicillium marneffei infection in AIDS. Pathol. Res. Int. 2011, 2011, 764293. [Google Scholar] [CrossRef]
- Sang, H.; An, T.J.; Kim, C.S.; Shin, G.S.; Sung, G.H.; Yu, S.H. Two novel Talaromyces species isolated from medicinal crops in Korea. J. Microbiol. 2013, 51, 704–708. [Google Scholar] [CrossRef]
- Shah, S.G.; Shier, W.T.; Tahir, N.; Hameed, A.; Ahmad, S.; Ali, N. Penicillium verruculosum SG: A source of polyketide and bioactive compounds with varying cytotoxic activities against normal and cancer lines. Arch. Microbiol. 2014, 196, 267–278. [Google Scholar] [CrossRef]
- Wu, Q.; Sun, R.; Ni, M.; Yu, J.; Li, Y.; Yu, C.; Dou, K.; Ren, J.; Chen, J. Identification of a novel fungus, Trichoderma asperellum GDFS1009, and comprehensive evaluation of its biocontrol efficacy. PLoS ONE 2017, 12, e0179957. [Google Scholar] [CrossRef] [PubMed]
- Meyer, R.; Plaskowitz, J.S. Scanning electron microscopy of conidia and conidial matrix of Trichoderma. Mycologia 1989, 81, 312–317. [Google Scholar] [CrossRef]
- Lieckfeldt, E.; Samuels, G.J.; Nirenberg, H.I.; Petrini, O. A morphological and molecular perspective of Trichoderma viride: Is it one or two species? Appl. Environ. Microbiol. 1999, 65, 2418–2428. [Google Scholar] [CrossRef]
- Samuels, G.J.; Lieckfeldt, E.; Nirenberg, H.I. Trichoderma asperellum, a new species with warted conidia, & redescription T. viride. Sydowia 1999, 51, 71–88. [Google Scholar]
- Jabnoun-Khiareddine, H.; Daami-Remadi, M.; Barbara, D.J.; El Mahjoub, M. Morphological variability within and among Verticillium species collected in Tunisia. Tunis. J. Plant Prot. 2010, 5, 19–38. [Google Scholar]
- Tsang, C.C.; Chan, J.F.; Pong, W.M.; Chen, J.H.; Ngan, A.H.; Cheung, M.; Lai, C.K.; Tsang, D.N.; Lau, S.K.; Woo, P.C. Cutaneous hyalohyphomycosis due to Parengyodontium album gen. et comb. nov. Med. Mycol. 2016, 54, 699–713. [Google Scholar] [CrossRef]
- Leplat, J.; François, A.; Bousta, F. Parengyodontium album, a frequently reported fungal species in the cultural heritage environment. Fungal Biol. Rev. 2020, 34, 126–135. [Google Scholar] [CrossRef]
- Sudiarta, I.P.; Suputra, I.P.W.; Wirya, G.N.A.S. New Report of Insect Pathogenic Fungi (Aschersonia sp.) of Citrus Whitefly (Dialeurodes sp.) in Bali Indonesia. Res. Agric. Vet. Sci. 2019, 3, 22–27. [Google Scholar]
- Deng, J.X.; Paul, N.C.; Sang, H.K.; Lee, J.H.; Hwang, Y.S.; Yu, S.H. First report on isolation of Penicillium adametzioides and Purpureocillium lilacinum from decayed fruit of Cheongsoo grapes in Korea. Mycobiology 2012, 40, 66–70. [Google Scholar] [CrossRef]
- Perdomo, H.; Cano, J.; Gené, J.; García, D.; Hernández, M.; Guarro, J. Polyphasic analysis of Purpureocillium lilacinum isolates from different origins and proposal of the new species Purpureocillium lavendulum. Mycologia 2013, 105, 151–161. [Google Scholar] [CrossRef]
- Kusai, N.A.; Mior Zakuan Azmi, M.; Zulkifly, S.; Yusof, M.T.; Mohd Zainudin, N.A.I. Morphological and molecular characterization of Curvularia and related species associated with leaf spot disease of rice in Peninsular Malaysia. Rend. Lincei 2016, 27, 205–214. [Google Scholar] [CrossRef]
- Fazio, A.T.; López, M.M.; Temperini, M.L.; de Faria, D.L.A. Surface enhanced Raman spectroscopy and cultural heritage biodeterioration: Fungi identification in earthen architecture from Paraíba Valley (São Paulo, Brazil). Vib. Spectrosc. 2018, 97, 129–134. [Google Scholar] [CrossRef]
- De Gelder, J. Raman Spectroscopy as a Tool for Studying Bacterial Cell Compounds Doctoral Disserta; Ghent University: Ghent, Belgium, 2008. [Google Scholar]

| Isolate No. | Species Name | Accession No. | The First Time Recorded in Malaysia | |
|---|---|---|---|---|
| 28S rRNA | ITS | |||
| EAN605 | Aspergillus iizukae | MK518343 | ND | |
| EAN506 | Aspergillus aculeatus | MK518351 | MK518394 | |
| EAN603 | Aspergillus arenarioides | MK518366 | ND | |
| EAN203 | Penicillium verruculosum | MK518350 | ND | |
| EFAQ406 | Penicillium crustosum | MK530088 | ND | |
| EAN604 | Penicillium pedernalense | MK518385 | ND | |
| EFAQ405 | Penicillium crustosum | MK530708 | MK530709 | |
| 102UTHM | Trichoderma viride | MK518057 | ND | |
| 303UTHM | Trichoderma asperellum | MK518056 | ND | |
| EAN601 | Purpureocillium lilacinum | MK518365 | ND | |
| EAN202 | Paraconiothyrium brasiliense | MK517572 | MK518445 | |
| EAN403 | Cochliobolus geniculatus | MK517569 | MK518444 | |
| 104UTHM | Schizophyllum commune | MK517570 | ND | |
| EAN602 | Parengyodontium album | MK518376 | ND | |
| EFAQ504 | Fusarium solani | MK530101 | ND | |
Disclaimer/Publisher’s Note: The statements, opinions and data contained in all publications are solely those of the individual author(s) and contributor(s) and not of MDPI and/or the editor(s). MDPI and/or the editor(s) disclaim responsibility for any injury to people or property resulting from any ideas, methods, instructions or products referred to in the content. |
© 2023 by the authors. Licensee MDPI, Basel, Switzerland. This article is an open access article distributed under the terms and conditions of the Creative Commons Attribution (CC BY) license (https://creativecommons.org/licenses/by/4.0/).
Share and Cite
Noman, E.A.; Al-Gheethi, A.A.; Talip, B.A.; Mohamed, R.M.S.R.; Almoheer, R.; Al-Wrafy, F.A.; Al-Shorgani, N.; El Enshasy, H.A. New Fungal Strains from Peat Soil in Malaysia: Morphological and Molecular Characteristics. Sustainability 2023, 15, 5902. https://doi.org/10.3390/su15075902
Noman EA, Al-Gheethi AA, Talip BA, Mohamed RMSR, Almoheer R, Al-Wrafy FA, Al-Shorgani N, El Enshasy HA. New Fungal Strains from Peat Soil in Malaysia: Morphological and Molecular Characteristics. Sustainability. 2023; 15(7):5902. https://doi.org/10.3390/su15075902
Chicago/Turabian StyleNoman, Efaq Ali, Adel Ali Al-Gheethi, Baliks A. Talip, Radin Maya Saphira Radin Mohamed, Reyad Almoheer, Fairoz Ali Al-Wrafy, Najeeb Al-Shorgani, and Hesham Ali El Enshasy. 2023. "New Fungal Strains from Peat Soil in Malaysia: Morphological and Molecular Characteristics" Sustainability 15, no. 7: 5902. https://doi.org/10.3390/su15075902
APA StyleNoman, E. A., Al-Gheethi, A. A., Talip, B. A., Mohamed, R. M. S. R., Almoheer, R., Al-Wrafy, F. A., Al-Shorgani, N., & El Enshasy, H. A. (2023). New Fungal Strains from Peat Soil in Malaysia: Morphological and Molecular Characteristics. Sustainability, 15(7), 5902. https://doi.org/10.3390/su15075902











